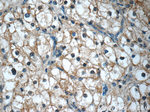
KIF12 Antibody in Immunohistochemistry (Paraffin) (IHC (P))
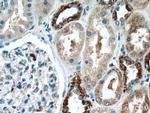
KIF12 Antibody in Immunohistochemistry (Paraffin) (IHC (P))

Search
Proteintech
KIF12 Polyclonal Antibody
{{$productOrderCtrl.translations['antibody.pdp.commerceCard.promotion.promotions']}}
{{$productOrderCtrl.translations['antibody.pdp.commerceCard.promotion.viewpromo']}}
{{$productOrderCtrl.translations['antibody.pdp.commerceCard.promotion.promocode']}}: {{promo.promoCode}} {{promo.promoTitle}} {{promo.promoDescription}}. {{$productOrderCtrl.translations['antibody.pdp.commerceCard.promotion.learnmore']}}
产品信息
12035-1-AP
种属反应
已发表种属
宿主/亚型
分类
类型
抗原
偶联物
形式
浓度
规格
纯化类型
保存液
内含物
保存条件
运输条件
产品详细信息
Immunogen sequence: MQRTFAWLL DRVQHLGAPV TLRASYLEIY NEQVRDLLSL GSPRPLPVRW NKTRGFYVEQ LRVVEFGSLE ALMELLQTGL SRRRNSAHTL NQASSRSHAL LTLYISRQTA QQMPSVDPGE PPVGGKLCFV DLAGSEKVAA TGSRGELMLE ANSINRSLLA LGHCISLLLD PQRKQSHIPF RDSKLTKLLA DSLGGRGVTL MVACVSPSAQ CLPETLSTLR YASRAQRVTT RPQAPKSPVA KQPQRLETEM LQLQEENRRL QFQLDQMDCK ASGLSGARVA WAQRNLYGML QEFMLENERL RKEKSQLQNS RDLAQNEQRI LAQQVHALER RLLSA (1-334 aa encoded by BC010626)
靶标信息
KIF12 encodes a member of the kinesin superfamily of microtubule-associated molecular motors with functions related to the microtubule cytosekelton. Members of this superfamily play important roles in intracellular transport and cell division. A similar protein in mouse functions in the beta cell antioxidant signaling cascade, acting as a scaffold for the transcription factor specificity protein 1 (Sp1). Mice that lack this gene exhibit beta cell oxidative stress resulting in hypoinsulinemic glucose intolerance.
仅用于科研。不用于诊断过程。未经明确授权不得转售。
生物信息学
蛋白别名: kinesin 12; kinesin superfamily protein 12; Kinesin-like protein KIF12; N-9 kinesin; RP1156P10.3
基因别名: KIF12; PFIC8
UniProt ID: (Human) Q96FN5, (Mouse) Q9D2Z8
Entrez Gene ID: (Human) 113220, (Rat) 313254, (Mouse) 16552